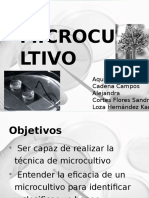
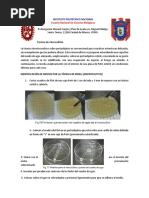

0% encontró este documento útil (0 votos)
2K vistas7 páginasPráctica 4. Microcultivos
1. El documento describe varias técnicas para la observación microscópica de hongos, incluyendo la preparación por disgregación (montaje húmedo), la técnica de cinta adhesiva de Scotch y la técnica de microcultivo.
2. La preparación por disgregación es rápida y económica pero puede dañar las estructuras fúngicas, mientras que la técnica de cinta adhesiva mantiene la estructura pero depende de la habilidad del operador.
3. La técnica
Cargado por
Diana MoraDerechos de autor
© © All Rights Reserved
Nos tomamos en serio los derechos de los contenidos. Si sospechas que se trata de tu contenido, reclámalo aquí.
Formatos disponibles
Descarga como PDF, TXT o lee en línea desde Scribd
0% encontró este documento útil (0 votos)
2K vistas7 páginasPráctica 4. Microcultivos
1. El documento describe varias técnicas para la observación microscópica de hongos, incluyendo la preparación por disgregación (montaje húmedo), la técnica de cinta adhesiva de Scotch y la técnica de microcultivo.
2. La preparación por disgregación es rápida y económica pero puede dañar las estructuras fúngicas, mientras que la técnica de cinta adhesiva mantiene la estructura pero depende de la habilidad del operador.
3. La técnica
Cargado por
Diana MoraDerechos de autor
© © All Rights Reserved
Nos tomamos en serio los derechos de los contenidos. Si sospechas que se trata de tu contenido, reclámalo aquí.
Formatos disponibles
Descarga como PDF, TXT o lee en línea desde Scribd